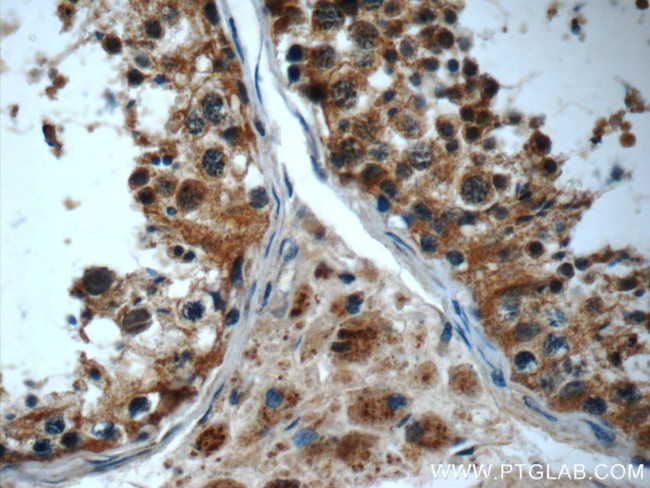
IFT43 Antibody in Immunohistochemistry (Paraffin) (IHC (P))
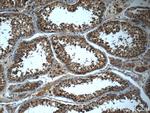
IFT43 Antibody in Immunohistochemistry (Paraffin) (IHC (P))

Search
Proteintech
IFT43 Polyclonal Antibody
{{$productOrderCtrl.translations['antibody.pdp.commerceCard.promotion.promotions']}}
{{$productOrderCtrl.translations['antibody.pdp.commerceCard.promotion.viewpromo']}}
{{$productOrderCtrl.translations['antibody.pdp.commerceCard.promotion.promocode']}}: {{promo.promoCode}} {{promo.promoTitle}} {{promo.promoDescription}}. {{$productOrderCtrl.translations['antibody.pdp.commerceCard.promotion.learnmore']}}
产品信息
24338-1-AP
种属反应
已发表种属
宿主/亚型
分类
类型
抗原
偶联物
形式
浓度
规格
纯化类型
保存液
内含物
保存条件
运输条件
产品详细信息
Immunogen sequence: MEDLLDLDE ELRYSLATSR AKMGRRAQQE SAQAENHLNG KNSSLTLTGE TSSAKLPRCR QGGWAGDSVK ASNGTQTGKQ QLDLNACYHK THHRNLGLAS LEEADIPIIP DLEEVQEEDF VLQVAAPPSI QIKRVMTYRD LDNDLMKYSA IQTLDGEIDL KLLTKVLAPE HEVREDDVGW DWDHLFTEVS SEVLTEWDPL QTEKEDPAGQ ARHT (1-213 aa encoded by BC010436)
靶标信息
IFT43, encoded by C14ORF179, is a subunit of the intraflagellar transport complex A (IFT-A) of primary cilia. The IFT-A is implicated in retrograde ciliary transport along axonemal microtubules. Defects in subunits of IFT-A has been associated with skeletal ciliopathies, including Sensenbrenner syndrome, Jeune syndrome, and Ellis-van-Creveld syndrome. Mutations in C14ORF179 has been linked to Sensenbrenner syndrome. (21378380).
仅用于科研。不用于诊断过程。未经明确授权不得转售。
生物信息学
蛋白别名: IFT complex A subunit; intraflagellar transport 43 homolog; Intraflagellar transport protein 43 homolog; unnamed protein product
基因别名: C14orf179; CED3; IFT43; RP81; SRTD18
UniProt ID: (Human) Q96FT9
Entrez Gene ID: (Human) 112752